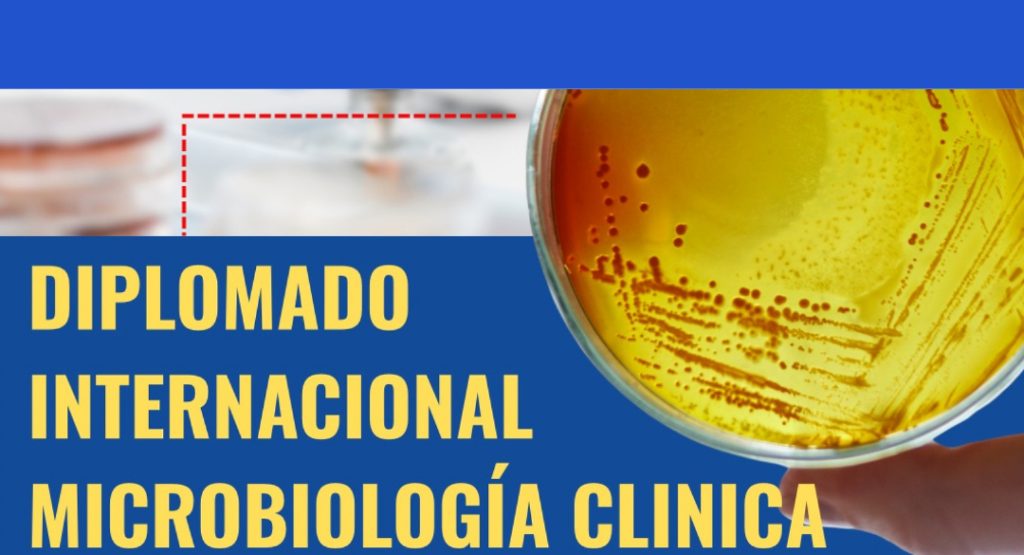

Estudio confirma sangre seca conserva su validez diagnóstica tras siete años a -80 °C

La conservación adecuada de muestras biológicas es un elemento clave para la investigación biomédica, la vigilancia epidemiológica y el control de enfermedades infecciosas. En este contexto, la Clínica Universidad de Navarra (CUN), a través de su Servicio de Microbiología, ha demostrado la fiabilidad a largo plazo de las muestras de sangre seca en papel, conocidas […]
Reconocen la excelencia científica con la entrega del Premio Nacional Louis Pasteur

La Asociación Dominicana de Microbiología (ADEMICRO) Inc. celebró con rotundo éxito el 1er Simposio Nacional de Microbiología (SINAM 2026), un evento histórico que reunió a profesionales, académicos, estudiantes e instituciones del sector científico nacional. Durante el acto central se realizó la entrega del Premio Nacional Louis Pasteur, máximo galardón que reconoce la trayectoria, el impacto […]
ADEMICRO abre convocatoria al Premio Nacional Louis Pasteur por el día nacional del microbiólogo

La Asociación Dominicana de Microbiología (ADEMICRO) anunció la apertura oficial de la Convocatoria al Reconocimiento a la Excelencia en Microbiología, en el marco de la celebración del Día Nacional del Microbiólogo Dominicano, que se conmemora cada 25 de enero. Por primera vez, la entidad invita a profesionales e instituciones del área a postularse o nominar […]
ADEMICRO abre convocatoria para Concurso de Tesis de Grado en Microbiología

La Asociación Dominicana de Microbiología anunció la Convocatoria Oficial para el Concurso de Tesis de Grado en Microbiología, que se celebrará durante el Simposio Nacional de Microbiología (SINAM) 2026. La iniciativa busca reconocer y promover el talento académico de estudiantes y jóvenes profesionales en las diversas ramas de la microbiología. El concurso está dirigido a […]
ADEMICRO anuncia primer diplomado internacional en microbiología clínica
La Asociación Dominicana de Microbiología (ADEMICRO) Inc., comprometida con la formación continua y el fortalecimiento profesional del gremio microbiológico, se honra en anunciar la realización del 1er Diplomado Internacional en Microbiología Clínica, programado para iniciar en el mes de septiembre de 2025. Este programa de formación especializada tiene como objetivo actualizar y profundizar los conocimientos […]
ADEMICRO sostiene reunión con la Dirección Nacional de Laboratorios del SNS

La Asociación Dominicana de Microbiología (ADEMICRO) Inc. marcó un importante precedente al sostener una reunión formal con la Dirección Nacional de Laboratorios Clínicos e Imágenes Médicas del Servicio Nacional de Salud (SNS), representada por su directora, la Lic. Yoany Maribel Arias Castro. Este encuentro tuvo como objetivo central discutir la inclusión activa de licenciados en […]
Asociación de Microbiología conmemora día y semana nacional con varios eventos

La Asociación Dominicana de Microbiología (ADEMICRO) Inc. celebró con gran entusiasmo el Día Nacional del Microbiólogo Dominicano y la Semana de la Microbiología Dominicana 2025, eventos en los que se rindió homenaje al Dr. Orangel Parada, pionero en la formación de microbiólogos en la República Dominicana. Esta edición especial de la semana estuvo marcada por […]
Intrusismo profesional en microbiología

Por Lic. Scarlet Morillo M.Sc Microbiólogo El intrusismo profesional en microbiología es un problema que ha afectado a la República Dominicana por muchos años, al igual que a muchos otros países en el mundo. Se trata de la práctica ilegal de personas que sin tener la formación académica y capacitación adecuada, ofrecen servicios relacionados con […]